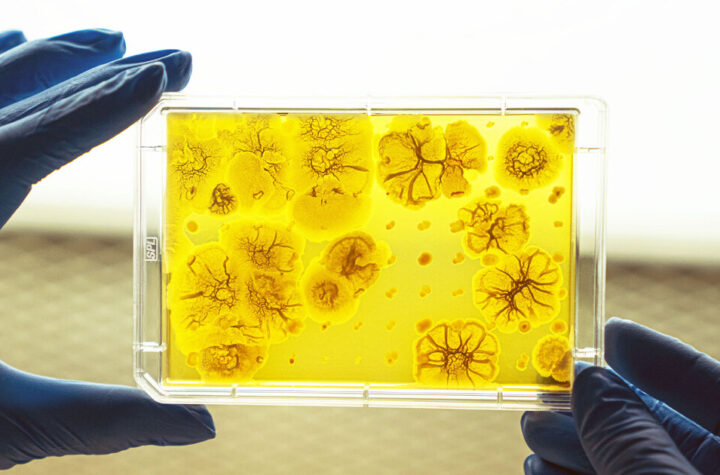

A store which specialises in the sale of international food has been fined thousands of pounds for selling out of...
Month: October 2022
Hello from the 2022 EPCOT International Food & Wine Festival! This year’s festival has all kinds of new and returning...
This cream cheese gingerbread fat bombs recipe is the perfect way to enjoy holiday treats and maintain your low carb...
Calbee S’pore addictive ‘Melts’ Potato Chips with Creamy Cheese Drizzles on sale for $4.85 in FairPrice By GDS Editorial Team...
Being part of a couple doesn’t always mean that you’ll share the same romantic interests. Indeed, sometimes you might love...
A lawsuit claims that billionaire James Leprino, whose family controls the world’s largest mozzarella producer, didn’t give his brother’s daughters,...
We’ve all had a vegan cheese that didn’t quite deliver when it came to flavor, melt, or texture. One Brooklyn...
Sign up for our What's On newsletter to keep your finger firmly on the pulse of an ever-changing Manchester We...
Beginning on Friday, July 15 at 6 p.m., you can get both your cheese fix and your cocktails too at the...
Rich vegan butter and macadamia milk meld with cashews to create silky smooth, nutty, cheesy sauce in this recipe from...